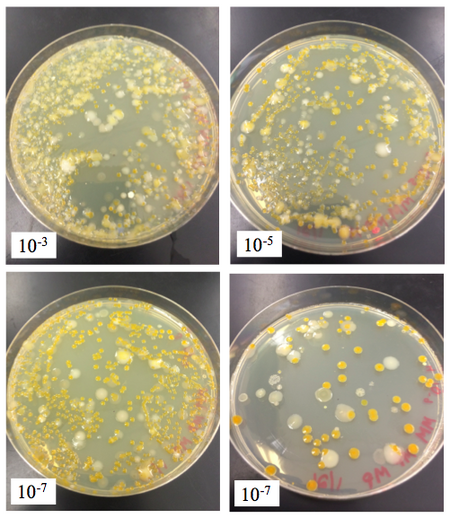
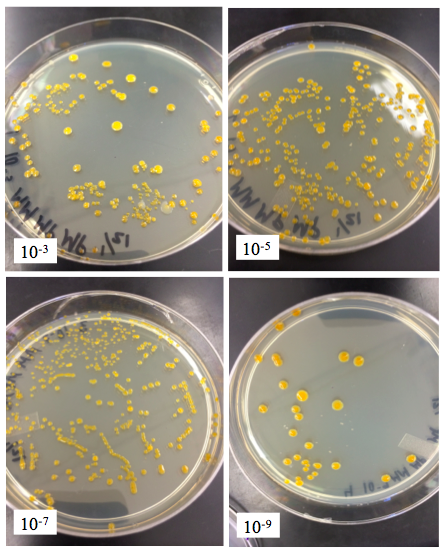

User:Mary L. Pavia/Notebook/Biology 210 at AU
Updated Zebrafish OpenWetWare, Observing the Developmental Effects of a 1.5% Alcohol Solution March 24, 2015
Purpose There is an undeniable relationship between the environment an embryo develops within and the embryo’s development due to their extreme sensitivity to their surrounding conditions (Bentley, 2015). Because of lack of control with human participants and the ease of conducting experiments on organisms that share similarities to humans, the experiment will investigate the effects of prenatal exposure using an animal model (Bilotta, 2004; Bentley, 2015). This experiment was created to study how the environmental condition of a 1.5% alcohol solution will affect the embryonic and early development of Zebrafish, the model freshwater organism observed, compared to a controlled environment void of alcohol.
Zebrafish are an excellent model organism, due to their small size and ease of development in vitro. Additionally, their development is similar to the embryogenesis in other vertebrates, such as humans. (“The Zebrafish as a Model Organism”, 2005).
Data & Observations Data Table (Could not figure out how to convert into a format that is easily readable via OWW)




Conclusions Our results support our hypothesis and prediction that embryos that develop in an experiment where alcohol is present will develop abnormally, and that if we grow Zebrafish embryos in a solution with a 1.5% alcohol concentration, then the body structure and eye size of the organism will be adversely affected compared to a controlled environment absent of alcohol. Additionally, we predicted that more Zebrafish embryos in the alcohol solution would die than the controlled embryos. We saw more mature development among the controlled fish, as well as more uniform normal growth. However, the experimental group did not develop as well as the control, and showed negative effects from the 1.5% alcohol solution. The fish in this group varied between one another in terms of development. Each fish looked unique and moved in slightly different, abnormal ways. Also, more test Zebrafish died at faster rates than the controlled group. Thus, we can deduce that alcohol has adverse effects on the development and lifespan during fetal development as seen by this model organism, the Zebrafish.
References Bentley, M., Walters-Conte, K., and Nancy K. Zeller. 2015. A Laboratory Manual to Accompany: General Biology II. Department of Biology, American University: Washington D.C.. 50-62. Bilotta, J., Barnett, J. A., Hancock, L., and Shannon Saszik. 2004. Ethanol exposure alters zebrafish development: A novel model of fetal alcohol syndrome. Neurotoxicology and Teratology. 26: 737-743. “The Zebrafish as a Model Organism”. Interfering early developmental genes. May 18, 2005. University of Madrid. (24 March, 2015).
-MLP
Zebrafish Lab: Observing the Developmental Effects of a 1.5% Alcohol Solution
Day 15 (March 4, 2015): Class Lab Day
Procedure/Methods 1. Observe the Zebrafish as well as the fixed control Zebrafish from last Wednesday (Day 8) 2. Fix two control larvae. Add the Zebrafish to a tube using a dropper and add one drop of tricaine solution per mL of water. Later, the TA added paraformaldehyde and stored the sample 3. Properly dispose of dead Zebrafish, put the living fish dishes to be preserved, and dispose of the alcohol solution in the waste collection jug
Data & Observations Control:
- # of Dead Eggs- 0
- # of Living Embryos still in Egg Cases- 0
- # of Living Hatchlings (Larvae)- 6
- # of Dead Hatchlings- 10
- Eye and Body Structure Observations- their eyes were moving, but very minimally; their bodies still had black speckles but were far more yellow in color than before; growth is noticeable in length of the fish. Today they were about 165 ocular spaces at 4x objective and on Monday they were 145 and a week ago (Day 8) were 140 ocular spaces; they still have a swim bladder that is about 10 ocular spaces wide at the x objective lens
- Other Observations- Some protists were found in their water; we used the fixed control Zebrafish to measure eye size of a controlled fish (12 ocular spaces at 4x lens); motility was much slower in pace and smaller range of motion compared to all other days of observation

- Fixed Zebrafish Larvae from February 25 (Day 8)

Test:
- # of Dead Eggs- 0
- # of Living Embryos still in Egg Cases- 0
- # of Living Hatchlings (Larvae)- 0
- # of Dead Hatchlings- 2
- Eye and Body Structure Observations- N/A (Dead)
- Other Observations- N/A (Dead)
Day 13 (March 2, 2015): Observation Day
Procedure/Methods 1. Added 10 mL fresh water to the control group and 10 mL of test solution to the experimental group. No water or alcohol solution was removed 2. Dead embryos/hatchlings were saved and put into paraformaldehyde 3. Observe the Zebrafish. a. Measured Heart Rate
Data & Observations Control:
- # of Dead Eggs- 0
- # of Living Embryos still in Egg Cases- 0
- # of Living Hatchlings (Larvae)- 16
- # of Dead Hatchlings- 1
- Eye and Body Structure Observations- Eyes are black and moving back and forth.
Body length = 145um, tail is long, making up most of the body. The body was yellow-colored and translucent with black speckles. The swim bladder measures about 10um.
- Other Observations- Heart rate measured 48/15 seconds. Swimming & behavior: The fish were lively and active, with fluid tail movements.

Test:
- # of Dead Eggs- 0
- # of Living Embryos still in Egg Cases- 0
- # of Living Hatchlings (Larvae)- 2
- # of Dead Hatchlings- 3
- Eye and Body Structure Observations- Eyes were black and not moving much. Head seemed to be smaller, and eyes closer together. The body measured about 155um, and was translucent with black speckles. The tail was shorter and fatter in comparison to the control. The swim bladder seemed to be absent/undeveloped, and as a result, the fish had problems staying balanced/upright in the water. (Kept rolling onto it’s side.)
- Other Observations- Heart rate was measured at 45/15 seconds.
Day 10 (February 27, 2015): Observation Day
Procedure/Methods 1. Removed 10 mL of water with any egg cases/dead hatchlings from each petri dish, and added 10 mL fresh water to the control group and 10 mL of test solution to the experimental group 2. Dead embryos/hatchlings were saved and put into paraformaldehyde 3. Observe the Zebrafish.
Data & Observations Control:
- # of Dead Eggs- 0
- # of Living Embryos still in Egg Cases- 0
- # of Living Hatchlings (Larvae)- 17
- # of Dead Hatchlings- 0
- Eye and Body Structure Observations- The fish all looked practically identical; eyes moves slightly and rotationally, but also in unison; straight body structure
- Other Observations- movement speed seemed to slow compared to the first few days

Test:
- # of Dead Eggs- 0
- # of Living Embryos still in Egg Cases- 0
- # of Living Hatchlings (Larvae)- 4
- # of Dead Hatchlings-1
- Eye and Body Structure Observations- body is much more yellow in color, and the tail proceeding the fish’s head was curved; the very abnormal fish observed on day 8 had shrank and was found dead in the dish
- Other Observations- the fish moved very rapidly but not at great distances. Also, motion required moving more of its body than control fish, that would only need to move their tails quickly for motility

Day 8 (February 25, 2015): Class Lab Day
Procedure/Methods 1. Removed 5 mL of water with any egg cases/dead hatchlings from each petri dish, and added 10 mL fresh water to the control group and 10 mL of test solution to the experimental group 2. Dead embryos/hatchlings were saved and put into paraformaldehyde 3. Add one drop of paramecium to each group of Zebrafish 4. From the control group (not the test group because there are not enough living fish to sacrifice one for preservation and it would be more beneficial to the experiment to continue observing their development), fix one larvae. Add the Zebrafish to a tube using a dropper and add one drop of tricaine solution per mL of water. Later, the TA added paraformaldehyde and stored the sample. Another fixation will occur in a week in the following lab. 5. Observe the Zebrafish.
Data & Observations Control:
- # of Dead Eggs- 0
- # of Living Embryos still in Egg Cases- 0
- # of Living Hatchlings (Larvae)- 18
- # of Dead Hatchlings- 0
- Eye and Body Structure Observations- Eyes were normal and rotated slightly, both eyes were the same size and moved in conjunction with one another; they moved in rapid short forwards bursts; body structure was normal and uniform among all of the hatchlings
- Other Observations- one control Zebrafish was preserved in the tricaine solution (see Procedure/Methods)

Test:
- # of Dead Eggs- 0
- # of Living Embryos still in Egg Cases- 0
- # of Living Hatchlings (Larvae)- 5
- # of Dead Hatchlings- 2
- Eye and Body Structure Observations- more yellow in color than the muted colored control fish; their movement was more spastic and used more upper body to move than just the tail; the fish varied in size; they generally had shorter and faster moving tails
- Other Observations- One fish (see image) moved very rapidly in place and showed difficulty moving

Day 6 (February 23, 2015): Observation Day
Procedure/Methods 1. Removed 10 mL of water and any empty egg cases from each petri dish 2. Remove any dead (fuzzy looking because mold grows on them) embryos 3. Add 25 mL of water to control dish 4. Add 25 mL of alcohol solution to test petri dish 5. Dead embryos were saved and put into paraformaldehyde 6. Observed Zebrafish
Data & Observations Control:
- # of Dead Eggs- 2
- # of Living Embryos still in Egg Cases- 0
- # of Living Hatchlings (Larvae)- 18
- # of Dead Hatchlings- 0
- Eye and Body Structure Observations- Uniform, nearly identical, proportional, large
- Other Observations- Lively and active
Test:
- # of Dead Eggs- 11
- # of Living Embryos still in Egg Cases- 0
- # of Living Hatchlings (Larvae)- 7
- # of Dead Hatchlings- 0
- Eye and Body Structure Observations- Small, bloated
- Other Observations- Lethargic
Day 3 (February 20, 2015):
Observation Day
Procedure/Methods 1. Removed 10 mL of water and any empty egg cases from each petri dish 2. Remove any dead (fuzzy looking because mold grows on them) embryos 3. Add 25 mL of water to control dish 4. Add 25 mL of alcohol solution to test petri dish 5. Dead embryos were saved and put into paraformaldehyde 6. Observed Zebrafish
Data & Observations Control:
- # of Dead Eggs- 0
- # of Living Embryos still in Egg Cases- 19
- # of Living Hatchlings (Larvae)- 1
- # of Dead Hatchlings- 0
- Eye and Body Structure Observations-
- Other Observations- All at or past 48 hour developmental stage; all of the embryos in the control are able to be seen in egg sac
Test:
- # of Dead Eggs- 2
- # of Living Embryos still in Egg Cases- 18
- # of Living Hatchlings (Larvae)- 0
- # of Dead Hatchlings- 0
- Eye and Body Structure Observations-
- Other Observations- Slows development and growth; 6 have embryo visible with naked eye, whereas all of the embryos in the control are able to be seen in egg sac
Day 1 (February 18, 2015): Class Lab Day
Hypothesis: Embryos that develop in an experiment where alcohol is present will develop abnormally.
I predict that if we grow Zebrafish embryos in a solution with a 1.5% alcohol concentration, then the body structure and eye size of the organism will be adversely affected compared to a controlled environment absent of alcohol. Additionally, I predict that more Zebrafish embryos in the alcohol solution will die than the controlled embryos.
Procedure/Methods 1. Create a hypothesis and prediction for the lab that will guide our research and experimental plan 2. Observed Zebrafish 3. Set up control group (20 mL of Deerpark water) and the test group (20 mL of 1.5% Alcohol) in covered petri dishes, both with 20 healthy translucent embryos per dish
Data & Observations
- # of Dead Eggs- 0 (both)
- # of Living Embryos still in Egg Cases- 20 (both)
- # of Living Hatchlings (Larvae)- 0 (both)
- # of Dead Hatchlings- 0 (both)
- Eye and Body Structure Observations- N/A (both)
- Other Observations- Small, <1mm in diameter, translucent; development approximately at the 20-somite developmental stage
-MLP
2.26.2015- 16S Sequence Analysis
Results: As previously mentioned, in our PCR reaction, there were two 1350 PCR DNA products of the 4 that our instructors purified for sequencing to identify the bacteria on the 16S rRNA gene, a gene commonly used to study bacterial phylogeny and taxonomy. One reason this is a helpful gene to observe and identify bacteria from is that this gene is present in almost all bacteria (Janda and Abbott, 2007). On February 25th, our results came back. We found out that the first bacterium bacterial sequences coded with over 99% likelihood to the Chryseobacterium sp. THG A18. This bacterium is Gram-stain-negative and rod-shaped (Park YJ, 2013). This supports our results from our Gram-stain procedure earlier in lab, since the bacterial colony extracted from the 10-3 nutrient agar was also Gram-negative and rod-shaped.
The second bacterium, however, went through a high background failure while being coded. However, enough of the sequence was coded to identify the bacterium with a 90% likelihood that it was a Klebsiella variicola strain. This is a gram-negative, rod-like bacterium that is a nitrogen-fixing bacterium (Rosenblueth, 2003). This also supports our findings, seeing as the bacteria extracted from the nutrient agar + Tetracycline at the 10-9 dilution was also Gram-negative and rod shaped.
References: Janda, Michael J. and Sharon L. Abbott. “16S rRNA Gene Sequencing for Bacterial Identification in the Diagnostic Laboratory: Pluses, Perils, and Pitfalls”. Journal of Clinical Microbiology. 11 July 2007. National Center for Biotechnology Information. (26 Feb 2015). Park YJ, et al. “Chryseobacterium gwangjuense sp. nov., isolated from soil”. International Journal of Systematic and Evolutionary Microbiology. 1 Aug 2013. National Center for Biotechnology Information. (26 Feb 2015).
Rosenblueth, Mónica, et al. “Klebsiella variicola, A Novel Species with Clinical and Plant-Associated Isolates”. Systematic and Applied Microbiology. 10 Oct, 2003. Bashan Foundation. (26 Feb 2015).
-MLP
2.18.2015: Lab 5- Invertebrates and Vertebrates"" '(Date of Entry was 2.18.2015, but the date in which we performed the lab was 2.11.2015)
Purpose: The purpose of this lab is to understand the importance of invertebrates and learn how simple systems evolved into more complex systems. I hypothesize that most of the invertebrates observed from our transect will be arthropods. If we observe collected organisms from the Berlese Funnel, then the majority of the invertebrates will be types of arthropods.
Materials & Methods: To study the invertebrates in our transect, we set up a Berlese Funnel the previous week to collect invertebrates. On this day in lab, we broke down the funnel and poured 10-15mLs of the liquid from the top into one petri dish, and the rest from the bottom of the liquid into another petri dish. Using a dissecting microscope and a dichotomous key, we observed and identified organisms collected with the Berlese Funnel.
We also went back to our transect to try to identify the vertebrates that inhabit and pass through out transect by looking at animal droppings, footprints, and visual spottings of various vertebrate species.
Data & Observations: The three types of worms we observed were the Nematode (roundworm), the Planaria, and the Platyhelminthes (flatworm). We saw that the Nematode is a pseudocoelom, meaning that this type of invertebrate has an incompletely lined body cavity. The planaria and the Platyhelminthes have no fluid filled cavities, so are considered acoelomates (Bentley, 2015). The Nematode moved by contracting its muscles and moving in almost a back-and-forth type of motion. The Planaria seemed to glide and crawl through fluid. Lastly, the Platyhelminthes’s motion could be described as twisting and gliding.

- After greater research, the phylum and class of this organism was Arthropoda, Insecta
Conclusions & Future Directions: My data supports my hypothesis that many of the invertebrates from transect 4 will be primarily types of arthropods (see the table under Data & Observations). Each known organism is an arthropod, and among our invertebrates, each arthropod is part of a different class. For example, soil mites are arachnida and the termites are insects. The unknown organism, Thrips, was the largest organism (2mm), and the soil mites and springtail were the smallest (1mm). Also, the soil mites were the most common invertebrate observed from the Berlese Funnel.
As noted in my data and observations, we observed three types of worms, their digestive anatomies, and their movement. The Nematode moved by contracting its muscles and moving in a back-and-forth type of motion. This can be attributed to the organism’s 4 separate muscle areas that contract to move. Because the Nematode is a pseudocoelom, the internal pressure increases and causes the stretching of the organism’s muscles in other parts, leading the roundworm to typically move on a horizontal plane (“Movement […]”). Next, the Planaria and the Platyhelminthes are both acoelomates and move similarly by gliding. Because of their simple internal digestive structures, they both have cilia that beat during normal locomotion and simple muscular structures (Speer, 2006; Stringer, 1917).
Vertebrate Common name (Phylum, Class) Dark-eyed junco (Chordata, Aves) Crow/ Corvus (Chordata, Aves) Rabbit (Chordata, Mammalia) Squirrel (Chordata, Mammalia) Rat (Chordata, Mammalia)
Characteristics that benefit each species:
- Biotic: insects, vegetation for food and to use for nests
- Abiotic: direct sunlight, irrigation hose (water), fence (protection)

References: Bentley, M., Walters-Conte, K., and Nancy K. Zeller. 2015. A Laboratory Manual to Accompany: General Biology II. Department of Biology, American University: Washington D.C.. 45-49.
“Movement using fields of muscles”. Nematodes. San Francisco State University. (17 Feb. 2015) <http://userwww.sfsu.edu/biol240/labs/lab_17hydrostaticsk/pages/nematode.html>
Speer, B.R. & Waggoner, Ben. “Introduction to the Platyhelminthes”. University of California Museum of Paleontology. 2006. University of California- Berkeley. (17 Feb. 2015) < http://www.ucmp.berkeley.edu/platyhelminthes/platyhelminthes.html>
Stringer, Caroline E. “The Means of Locomotion in Planarians”. Zoology. 29 Oct. 1917. JSTOR. (17 Feb. 2015) <http://www.jstor.org/stable/83790?seq=1#page_scan_tab_contents>
-MLP
2.11.2015: Lab 4- Plantae and Fungi (Date of Entry was 2.11.2015, but the date in which we performed the lab was 2.4.2015)
Purpose: To appreciate the characteristics and diversity of plants, and to appreciate the function and importance of fungi. In this lab, I hypothesize that if we analyze organisms (plantae or fungi) from our transect, then there we will observe diversity in terms of mechanisms of plant reproduction, vascularization, and specialized structures. I predict that there will be similarities between some of the produce and the mushroom will be the most different.
Materials & Methods: For the first activity, we traveled to our transect with Ziplock bags. In the first, we gathered a 500g leaf litter sample from out transect. This was used to set up a Berlese funnel for collecting invertebrates. In this Berlese Funnel method, we poured 25 mL of the 50:50 ethanol water solution into the 50 mL conical tube. A piece of screening material was fit into the bottom of the funnel and taped so the leaf litter will not fall into the preservative. The leaf litter sample was placed in the top of the funnel. The funnel was on a ring stand so that it was held into the tube with the ethanol. The base of the funnel and tube was covered with Parafilm so the ethanol wouldn’t evaporate. A 40 watt lamp placed above the funnel. Then, everything was covered with foil. The funnel was left for one week.Next, we took representative samples from 5 different plants in a minimally damaging way. We took a Brussels sprout and a kale leaf from their respective vegetation boxes, a clover weed and a bristled tan weed from the pathway in between two boxes, and a mushroom that was growing on the side of the lettuce planter box. Back in lab, we examined the plants and fungi using light microscopy.
Also, we ran the PCR products on an agarose gel and were able to observe the results today.
Data & Observations: PCR Results:

Image 1:

Image 2:

Image 3:

Image 4:

Image 5:

Plantae and Fungi Observations and Characteristics

Image of Fungi (basidiomycota)

The Brussels sprout plant had its flowering bulbs inside of leafy stalks. The plants were over a decimeter tall. The kale plant is almost entirely leafy, but are arranged in smaller bushel-like structures. The mushroom had no leaves, nor did the bristled weed we found on the ground. The clover weed, however, was taken from a patch of clover that was growing low on the ground and spread form the lettuce planter box into the pathway.
In our transect, we could not find drop seeds and none were present. However, we could find some evidence for mechanisms of reproduction based on our other observations.
Conclusions & Future Directions: The results supported my hypothesis that the mushroom will be the most different among the 5 organisms. Three of our five plant samples except for the mushroom and bristled weed were angiosperms. The mushroom was a basidospore and also had rhizoids. We observed xylem and phloem in the Brussels sprout, bristled weed, and the clover weed. The bristled weed was a seedless vascular plant.
Fungi sporangia are decomposers with small, black, spherical structures called sporangia. Inside of the sporangia are spores. They are important because they fill a niche that is necessary for the biosphere since they metabolize decaying organisms and release carbon dioxide and nitrogenous materials into the soil (Bentley, 2015). Above is the picture entitled the Image of Fungi. It is a fungus that belongs to the basidiomycota. This is known because it is a mushroom and sexual basidiospores are produced on the underside of the mushroom cap.
As mentioned in Materials and Methods, we set up a Berlese funnel for collecting invertebrates. Next week’s lab is focused on identifying and analyzing various invertebrates from the sample.
In our PCR reaction, there were two 1350 PCR DNA products of the 4 that our instructors will purify for sequencing to eventually identify the bacteria.
References: Bentley, M., Walters-Conte, K., and Nancy K. Zeller. 2015. A Laboratory Manual to Accompany: General Biology II. Department of Biology, American University: Washington D.C.. 42.
-MLP
2.3.2015: Lab 3- Microbiology and Identifying Bacteria with DNA Sequences (Date of Entry was 2.3.2015, but the date in which we performed the lab was 1.28.2015)
Purpose: To understand the characteristics of different bacteria found in our transects, observe any antibiotic resistance the bacteria might have, and understand how DNA sequences are used to identify species through PCR. My hypothesis for this lab is that there will be more bacterial growth in the nutrient agar plates than on the nutrient agar plates that also include the antibiotic tetracycline. Also, I do not think that any Archaea species will have grown on the agar plates because the environments will not be extreme enough for them to develop in. If we observe the two conditions (NA and NA+Tet), then there will be more types and a higher quantity of bacteria on the NA plates. Additionally, the higher the dilution, I predict the fewer number of bacteria present on the agar plates.
In regards to the Hay Infusion Culture, my hypothesis as to why the appearance might have changed from week to week is because of the decomposition rate of some of the plantae within the culture and the environment, which could nurture some bacteria more than others.
Materials & Methods: In this lab, we observed the 8 agar plates that we prepared the previous week. We looked at the physical plates, and used microscopy to observe bacterial colonies from various plates. We first used a wet mount procedure by sterilizing a loop over a flame, scraping off a small amount of growth from the agar surface, mixing the bacteria into a drop of water on a slide, and covering it with a cover slip. Next, we used a Gram Stain procedure to better characterize the bacteria. To do this, we put bacteria in a drop of water on a slide, and head fix the air dried slide by passing it through a flame. Then, we covered the bacterial smear with crystal violet for a minute and rinsed the slide, covered the smear with Gram’s iodine for a minute and rinsed the stain off. We decolorized the smear by flooding it with 95% alcohol and then rinsing it off. Lastly, we covered the smear with safranin stain and rinsed off the stain. After allowing the slide to dry, we were able to focus on the gram stained sample to identify whether or not each bacterium were Gram positive or negative.
To set up for part of next week’s lab, we prepared PCR for 16S sequencing. We isolated DNA from the bacteria in the colonies and used primers and PCR to selectively amplify the 16s rRNA gene. So, we transferred a colony of bacteria into a sterile tube, incubated at 100°C for 10 minutes, centrifuged the samples for 5 minutes at 13,400 rpm, and then added 20 μL of primer/water mixture to a PCR tube. Lastly, 5 μL of supernatant from the centrifuged samples were transferred to the 16S PCR reaction.
Data & Observations:
Transect After 2 Week Incubation

The sample smelled the same as the previous week. The water was less clouded but there was more plant matter and sediment at the bottom of the jar. There was also less plant matter floating in transect. The plant needles were still mostly in tact.
Table 1: 100-fold Serial Dilutions Results

Table 2: Bacteria Characterization

Nutrient Agar Plates
- the bottom right plate should be labeled 10^-9 instead of 10^-7
Nutrient Agar + Tet Plates
Conclusions & Future Directions: The results supported my hypothesis that, generally, there was more bacterial growth on the nutrient agar plates that did not contain the antibiotic, and that bacterial growth tended to decrease as the dilution increased. This indicates that the tetracycline is effective against a few types of bacteria present in the transect, but not all. For example, a white-colored bacteria is present in the NA plates, but not the NA+tet plates, demonstrating that this bacteria is sensitive to this type of antibiotic. The yellow/orange bacteria seen in both samples could be insensitive to tetracycline, or antibiotic-resistant in general. However, a few findings did not support my hypothesis exactly. On the plates without tetracycline, there was more bacterial growth on the plate with a concentration of 107 than the 105 NA plate. Similarly, the 103 NA+Tet plate had fewer bacterial colonies observed than the 105 plate. This could be because of the carrying capacities of the agar plates based on the bacteria present.
Tetracycline, the antibiotic used in this lab, is now ineffective against a growing number of pathogenic, opportunistic, and commensal bacteria. It inhibits bacterial protein synthesis. Many types of bacteria are sensitive to the antibiotic, such as vaious gram-positive and gram-negative bacteria, chlamydiae, mycoplasmas, rickettsiae, and protozoan parasites (Chopra, 2001).
Next week, we will use the PCR products made from this week’s lab and run them on an agarose gel to determine the DNA sequences of the bacteria.
References: Chopra, Ian & Roberts, Marilyn. “Tetracycline Antibiotics: Mode of Action, Applications, Molecular Biology, and Epidemiology of Bacterial Resistance”. Microbiol Mol Bio Rev. June 2001. National Institue of Health. (2 Feb. 2015) <http://www.ncbi.nlm.nih.gov/pmc/articles/PMC99026/>
-MLP
1.27.2015: Lab 2- Identifying Algae and Protists: Hay Infusion Culture Observations; Preparing and Plating Serial Dilutions (Date of Entry was 1.27.2015, but the date in which we performed the lab was 1.21.2015)
Purpose: In this lab, our purpose was to examine algae and protists from our transect through observations and the use of a dichotomous key. Our goal was to determine the identity of organisms using the key, and try to identify as many different organisms as possible from different niches within our Hay Infusion Culture, which is even considered an ecosystem (Bentley, 2015). My hypothesis is that there will be few differences between organisms found in different niches within the culture. If we use a dichotomous key to identify organisms from different niches, then we will observe and identify similar organisms in both niches.
Materials & Methods: Firstly, we took visual and olfactory observations of our Hay Infusion Culture that had been sitting undisturbed in an area in the lab for a week. After observing the culture, we took samples for microscopic observation from two different niches: on the very top surface and within the very bottom, mucky layer of the jar. Next, we made wet mount slides from the two samples drawn from the culture. Using the dichotomous key, we identified organisms (protists and algae) by making a series of two morphological choices. The organisms needed to also be measured using an ocular micrometer, and their sizes recorded.
In the second part of lab, we prepared and plated serial dilutions for the next week’s microbiology lab. To do this, we labeled four tubes of 10 mL sterile broth with 10-2, 10-4, 10-6, and 10-8. Using a micropippettor set at 100 microliters and clean tips, we transferred 100μL from the recently gently swirled culture to the 10 mL sterile broth tube labeled 10-2. This created a 1:100 dilution. Next, we swirled the tube, used a clean tip to transfer 100μL from the 10-2 tube to inoculate tube 10-4. This process of serial dilution was repeated two more times to create a 10-6 and 10-8 dilution. We plated the serial dilutions on four nutrient agar plates and four nutrient agar plates plus tetracycline. To do this, each plate was labeled. One of each type of agar plate was labeled 10-3, 10-5, 10-7, and 10-9, and the four plates with tetracycline were also labeled with “tet”. After the plates were labeled, we pipetted 100μL from the 10-2 tube onto the two nutrient agar plates labeled “10-3”. The sample was then spread carefully across the agar. This procedure of plating was repeated with the 10-4 dilution on the 10-5 plates, the 10-6 dilution on the 10-7 plates, and the 10-8 dilution on the 10-9 plates. After each agar plate was prepared, they were set-aside upside down in a rack so they would safely incubate at room temperature for a week.
Data & Observations: The culture smelled moist, rancid, and pungent. As seen in image 1, the culture was semi-transparent, with plant matter floating at the top of the sample. At the bottom of the sample (seen in images 2 and 3), there was a darker muck layer composed of mostly soft, wet soil. There was mold on top of the culture and was growing up the sides of the jar. On a decomposing leaf floating on top of the liquid, white specks of mold grew. There was more mold growing on a lot of the plant matter. The pine needle in the culture was fairly in tact, while the Brussels sprout was shriveled up and smaller in size than when it was initially added to the Hay Infusion Culture.

Image 1

Image 2

Image 3
From the bottom layer niche, organisms observed were Paramecium Aurelia (130 μm, motile), Gonium (colony 90 μm in diameter, non-motile), and Colpidium sp. (60 μm, motile).
From the bottom layer niche, organisms observed were Pelomyxa (2mm, motile, pseudopodia), Paramecium Aurelia (140 μm, motile) and Pandorina (colony 85 μm, non-motile).
All organisms observed are protozoa and are not photosynthesizing organisms.
Image 4 shows the Paramecium Aurelia observed through a microscope from the bottom layer niche

Figure 1 is a dilution table that illustrates the serial dilution procedure used in the lab. The reason the nutrient agar plates are labeled 10-3, 10-5, 10-7, and 10-9 is because the 100 microliters used to inoculate the surface of the agar is considered another ten-fold dilution.




Conclusions & Future Directions: While my data mostly refutes my hypothesis that there will not be drastic differences between the niches, there were some organisms observed in both niches, as expected. Paramecium, for example, was present in the top layer and bottom layer niche.
The organisms might differ close to verses away from the plant matter because the plants could attract various organisms to them as food or shelter. However, other organisms may not need nutrients from the plants or even prefer to live in different environments, such as a less oxygen present area like the one that exists in the bottom layer amidst the wet soil.
If the Hay Infusion Culture “grew” for another two months, I predict that all of the plant matter would decompose, and mold would infest the culture so much that the carrying capacity of the culture could not have space for many other organisms besides the mold. Or, stronger individuals with higher fitness based on the ecosystem will survive and repopulate and inhabit the culture.
Next lab, we will use the plates of serial dilutions to observe prokaryotic organisms and maybe fungi from the Hay Infusion Culture.
References: Bentley, M., Walters-Conte, K., and Nancy K. Zeller. 2015. A Laboratory Manual to Accompany: General Biology II. Department of Biology, American University: Washington D.C.. 22-23.
-MLP
1.25.2015: Lab 1- Biological Life at AU: Observing a Niche at AU (Date of Entry was 1.25.2015, but the date in which we gathered observations and collected a sample from the transect was 1.14.2015)
Purpose: I am analyzing a particular transect (group 4) on the American University main campus to better understand the organisms that inhabit the land, the biotic and abiotic factors that affect the niche, and how all of these factors interact within the different niches in the transect (Bentley, 2015). On the 14th of January, we went to our location to gather observations about it and collected a sample of soil/ground vegetation from the ecosystem that became a Hay Infusion Culture. My hypothesis is that we will observe fewer organisms and factors than are truly present. If we only complete visual observations of the area, then we will record fewer biotic (and abiotic) factors than we will find when carrying out closer microscopic observations of our Hay Infusion Culture.
Materials & Methods: After embarking to the group 4 designated transect and documenting the biotic and abiotic factors observed, we collected a sample of soil and ground vegetation in a sterile 50 mL conical tube. We were sure to collect a diverse group of plant matter so that our sample was representative of our specific transect. After returning to lab, we placed 10-12 grams of the sample into a clean, plastic jar with 500 mLs of Deer Park® water and 0.1 gm of dried milk. Then we put a lid on the jar so that we could carefully mix the contents of it for 10 seconds. Finally, we removed the lid of the jar and placed the open jar in the lab and let it remain there for one week.
Data & Observations:
Figure 1. An Aerial-View Diagram of Group 4’s 20 by 20 meter Transect

Figure 1 is an aerial-view Diagram of my group’s (group 4) 20 by 20 meter ecosystem. The transect was in part of a small farm garden located behind the tennis courts on the western side of the American University main campus. The four smaller rectangles represent the wooden planter boxes in the garden where 4 types of vegetation grow: Brussels sprouts, lettuce, kale and cucumber. The main features in between and outside of the boxes on the ground are woodchips, soil, decomposing plant matter, and some weeds. The compass is provided to indicate navigation of the transect.
Figure 2: Observations about the Biotic and Abiotic Characteristics of Group 4’s Transect

Figure 2 is a table listing the biotic and abiotic factors within the transect in the farm garden observed on Wednesday, January 14, 2015 during the late afternoon lab period.

Image 1 shows the Brussels sprout planter box, as well as the decomposing plant matter on top of the soil within the box. The image also displays the wood chipped pathway in between the boxes within the fenced in farm garden.

Image 2 depicts the kale and cucumber planter boxes. The kale planter box has over 15 sprouted kale plants and an irrigation hose is present within the box. Also, a small scarecrow is lying in the far southwestern corner of the box. In the cucumber planter box, there are no apparent signs of cucumber plant grown above the surface of the soil.

Image 3 is of the lettuce planter box. The northwestern corner of the box is home to one lettuce plant. Snow is inside of the planter box as well.

Image 4 shows the south and southeastern side of the transect, where the 5 shrubs are present. Plant matter surrounds each individual plant.
Conclusions & Future Directions: As previously noted within the Data & Observations section, the transect was within a fenced off area with a gated entryway. This could be important, as it possibly reduces foot traffic of humans and animals, limits quantity of pests in the garden, and contamination of area in general. The animal waste found within the ecosystem indicates that, while no animals were seen at that time, there is clear evidence of animal interaction with transect (ie. Rabbit). Lastly, the small shrubs near the southeastern side of the transect against the fence were surrounded by decomposing plant matter. This looked intentional and was probably laid down for insulation of the plants during the cold winter months. According to the BBC, cold weather can have damaging effects on the cellular make-up of plants. Because of this, layering plant matter around the bases of plants can minimize the damage of cold temperatures (“Cold weather”, 2014).
My hypothesis was that we will observe fewer organisms and factors than are truly present. I predicted that if we only complete visual observations of the area, then we will record fewer biotic (and abiotic) factors than we will find when carrying out closer microscopic observations of our Hay Infusion Culture. While the hypothesis did not truly address the original purpose of the lab, the hypothesis is necessary and will still be applicable for the second part of the lab. Next lab period, we will use the Hay Infusion Culture created in this lab to test my hypothesis and attempt to identify different organisms and protists in the sample by using a dichotomous key. We will also observe the cultures after the week incubation period and find different niches within the one culture. To finish lab, we will prepare and plate serial dilutions to prepare for the next week’s microbiology lab.
References: Bentley, M., Walters-Conte, K., and Nancy K. Zeller. 2015. A Laboratory Manual to Accompany: General Biology II. Department of Biology, American University: Washington D.C.. 16.
“Cold weather”. Gardening guides. 2014. BBC. (25 Jan 2015) <http://www.bbc.co.uk/gardening/basics/weather_coldweather.shtml>
-MLP
1.20.2015: I'm am able to access OpenWetWare and submit content for Biology 210.
-MLP